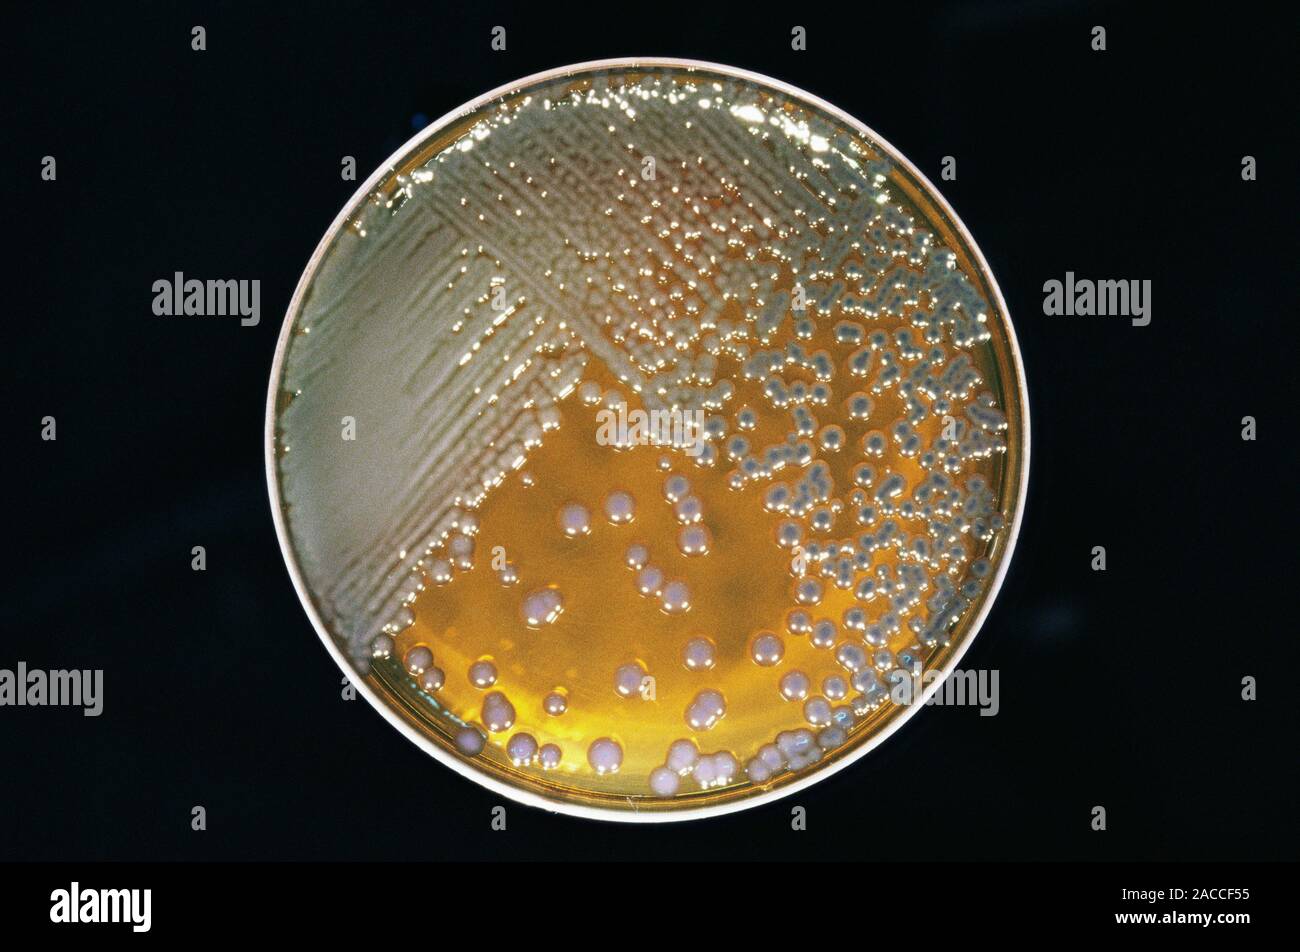
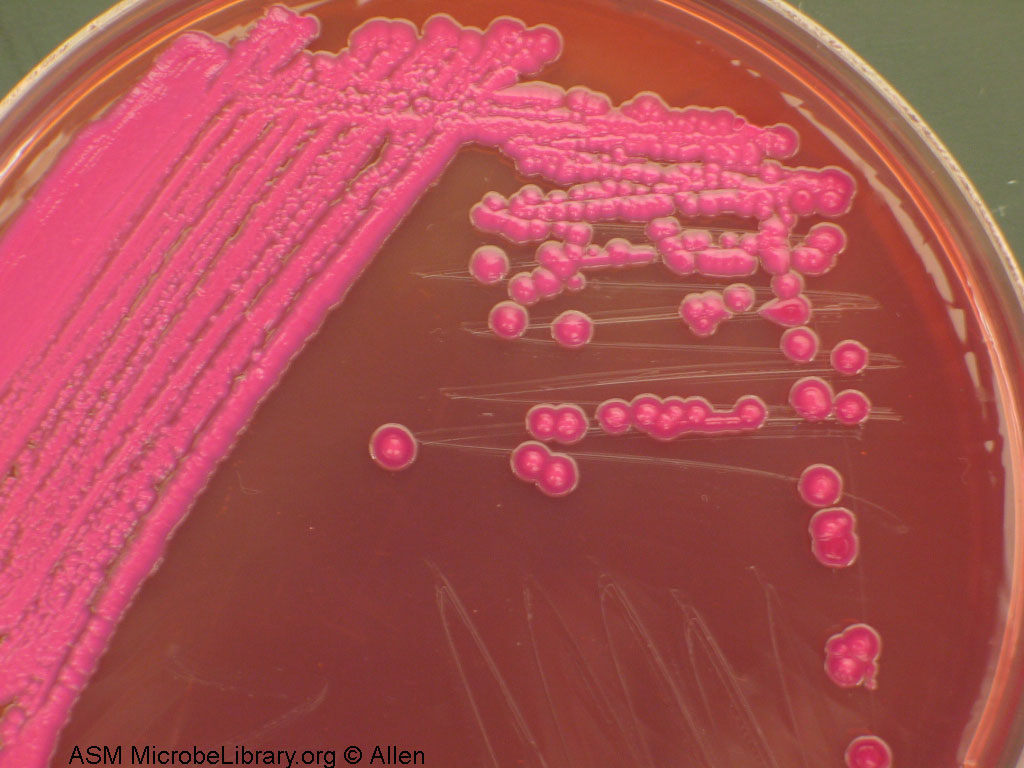

лла условно патогенная
Клебсиелла условно патогенная 109 фото
Гисметео городец на 10 дней погода нижегородской
The inmost light
Мосэнергосбыт в троицке
Клавиатура с мышью для телефона
Как расслабить седалищные мышцы
21 2021 год год чего
Render установка
Алгебра номер 316
Гарлин 500
Замена втулок витара